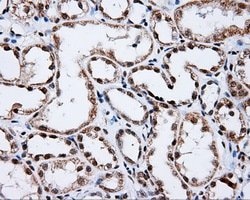
SHC1 Mouse anti-Human, Clone: OTI3A1, lyophilized, TrueMAB 100 &mu;g; Unconjugated:Antibodies,
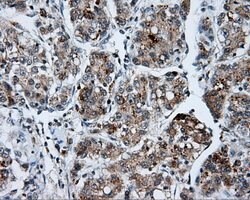
SHC1 Mouse anti-Human, Clone: OTI3A1, lyophilized, TrueMAB 100 &mu;g; Unconjugated:Antibodies,

Learn More
SHC1 Mouse anti-Human, Clone: OTI3A1, lyophilized, TrueMAB™
Mouse Monoclonal Antibody
Brand: Origene Technologies CF501056

Description
Reconstitute with PBS (pH 7.3) and recommend to perform another round of desalting process using Product No. 7KMWCO
Signaling adapter that couples activated growth factor receptors to signaling pathways. Participates in a signaling cascade initiated by activated KIT and KITLG/SCF. Isoform p46Shc and isoform p52Shc, once phosphorylated, couple activated receptor tyrosine kinases to Ras via the recruitment of the GRB2/SOS complex and are implicated in the cytoplasmic propagation of mitogenic signals. Isoform p46Shc and isoform p52Shc may thus function as initiators of the Ras signaling cascade in various non-neuronal systems. Isoform p66Shc does not mediate Ras activation, but is involved in signal transduction pathways that regulate the cellular response to oxidative stress and life span. Isoform p66Shc acts as a downstream target of the tumor suppressor p53 and is indispensable for the ability of stress-activated p53 to induce elevation of intracellular oxidants, cytochrome c release and apoptosis. The expression of isoform p66Shc has been correlated with life span. Participates in signaling downstream of the angiopoietin receptor TEK/TIE2, and plays a role in the regulation of endothelial cell migration and sprouting angiogenesis.Specifications
| SHC1 | |
| Monoclonal | |
| Unconjugated | |
| SHC1 | |
| SHC, SHCA | |
| Mouse | |
| Affinity Chromatography | |
| RUO | |
| 6464 | |
| -20° C, Avoid Freeze/Thaw Cycles | |
| Lyophilized |
| Immunocytochemistry, Immunofluorescence, Immunohistochemistry (Paraffin), Western Blot | |
| OTI3A1 | |
| PBS with 8% trehalose and no preservative; pH 7.3 | |
| P29353 | |
| SHC1 | |
| Full length human recombit protein of human SHC1 produced in HEK293T cell. | |
| 100 μg | |
| Primary | |
| Human | |
| Antibody | |
| IgG1 |
The Fisher Scientific Encompass Program offers items which are not part of our distribution portfolio. These products typically do not have pictures or detailed descriptions. However, we are committed to improving your shopping experience. Please use the form below to provide feedback related to the content on this product.